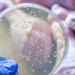
Prof. Dr. Yaşar Bayındır’dan salmonella enfeksiyonu uyarısı

Trakya’da ayçiçeğine alternatif olarak ekilen ve çiftçinin ‘sarı altın çiçek’ olarak adlandırdığı kanolayı kuraklık vurdu.
Trakya’nın sarı altın çiçeği kanola, bölge yağış alamayınca yaşanan kuraklığa yenik düştü. Ayçiçeğine alternatif olarak ekimi Trakya’da her geçen yıl artan kanolada, yüzde 50’lere varan verim kaybı yaşandı. Edirne’de 20 bin 713 dekar ekilen kanola, bitkisel yağ üretimi ile biyodizelde kullanılıyor.
‘ŞU ANDA TAMAMEN İŞİMİZ UMUT’
Edirne Lalapaşa Ziraat Odası Başkanı Taner Öztürk, 15 Eylül’den itibaren ekim ayının başına kadar üreticilerin kanola ekimi yaptığını belirterek, “Bu sene de oldukça yoğun bir ekim oldu. Müthiş bir eylül sıcakları, ekim sıcakları topraktaki tavın gitmesine sebep oldu. Beklenen mevsimsel yağışlarda gelmediğinden dolayı şu anda kanolalarda ekilenlerin yüzde 50’si ölmüş durumda, yüzde 50’si de can çekişmekte. Eğer son 3-4 gün içinde veya bir hafta içinde yağmur gelmese, bu kanolalar da bozulacaktır. Büyük bir milli kayıp. Mevsim normallerinin yağışları çok geç kalmış olmasına rağmen bugünlerde yağmur yağarsa arkasından da belli bir ısı seviyesinde durursa, çok aşırı eksilere düşmezse gelişimi tamamlamasını umut ediyoruz. Şu anda tamamen işimiz umut” dedi.

‘BU KADAR YÜKSEK SICAKLIKLA HİÇ KARŞILAŞMADIK’
Özellikle eylül ayı içerisinde ekilen kanolaların yüzde 50’sinde verim kaybı yaşandığını anlatan Öztürk, “Artık onları yağışlar da kurtaramaz. Yağış olsa büyüyecek, kuruyor. Şu anda toprağa da baktığımız zaman bir gram nem yok, tav yok. Bunların ne olacağını yağışların sonra göreceğiz, böyle bir şey ile ilk defa karşılaştık. Şu anda Trakya’da, Edirne’de bence yüzyılın kurağını yaşıyoruz. Buğdaylar da tamamen kuruya ekildi. Bu zamana kadar çıkmaları gerekiyordu ki gelişim evrelerini tamamlasın. Kanolalar evrelerini tamamlayamazsa yarın aralık, ocak ve şubat soğuklarında ne olacaklarını hep beraber göreceğiz. Bu şekilde kurağa ekimler yaptık ama bu kadar uzun süre yağışın gelmemesi, artı bu kadar yüksek derecede sıcaklıklar ile hiç karşılaşmadık. 30-35 dereceleri gördük. Bu sıcaklıklarla hiç karşılaşmadık. Biraz az yağış alırdı ama ısı düşük olduğundan dolayı o nem giderdi. Ama gerçekten yaz ayı sıcaklıkları kadar olduğundan böyle bir şeyi hatırlayan yok” diye konuştu.
‘ÇOK MALİYETLİ BİR ÜRÜN’
Öztürk, “Ayçiçeğinde bazı bölgelerde neredeyse sıfıra yakın verim alındı. Üreticiler daha önce de kanola ekiyordu; ama bu sene yoğun bir ekim oldu. Üretici bir umutla ekti. Fakat iklimsel değişiklikler eylül ve ekim ayında da devam ettiğinden dolayı bu sefer kanolada da hüsrana uğradı. Çok masraflar yapıldı. İlacı, gübresi ve işçilik olarak çok maliyetli bir ürün. Kışlık bir mahsul olduğu için bizim bölgemizde yaklaşık 200 ile 350 kilogram arasında verim sağlıyordu. Geçtiğimiz sezon en iyi fiyatın kanolada olmasından dolayı üreticiler de tercih etti. Ama maalesef yine iklim değişikliğine yenildi” dedi.